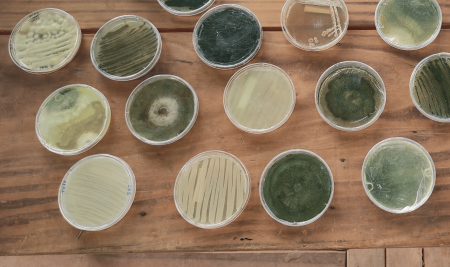
Podridão-de-Fusarium na Seringueira: Uma Ameaça Silenciosa para a Indústria da Borracha

É o Controle Biológico

E Saia na Frente
Seleção de Colaboradores AD Hoc 2026 Se Candidate para uma das 27 vagas no Brasil
Registre-se Agora
Faça parte do Portal dos Biológicos no Brasil e se Candidate ao Nosso Time.
Eventos
Próximos eventos sobre Controle Biológico no Brasil
Últimas Notícias
Notícias sobre Controle Biológico no Brasil.
Portal dos Biológicos no Brasil
26/01/2024
Portal dos Biológicos no Brasil, a maior e mais abrangente plataforma sobre Controle Biológico no país
Portal dos Biológicos no Brasil
16/01/2024
Microrganismos eficientes – Uma Mentira ou Uma Solução?
Portal dos Biológicos no Brasil
17/01/2024
O que é e para o que serve o Bacillus thuringiensis ?
Portal dos Biológicos no Brasil
18/01/2024
Radar Tecnológico revela 954 patentes de Bioinsumos para a Agricultura
Portal dos Biológicos no Brasil
19/01/2024
Podridão-de-Fusarium na Seringueira: Uma Ameaça Silenciosa para a Indústria da Borracha
Portal dos Biológicos no Brasil
20/01/2024
Você sabe mesmo sobre os Inoculantes Biofertilizantes ?
O que as Pessoas Dizem
Comentários sobre o Portal dos Biológicos no Brasil.
Cadastre o seu melhor e receba notícias da semana, materiais educacionais, novos cursos, posts interessantes, livros populares e muito mais!